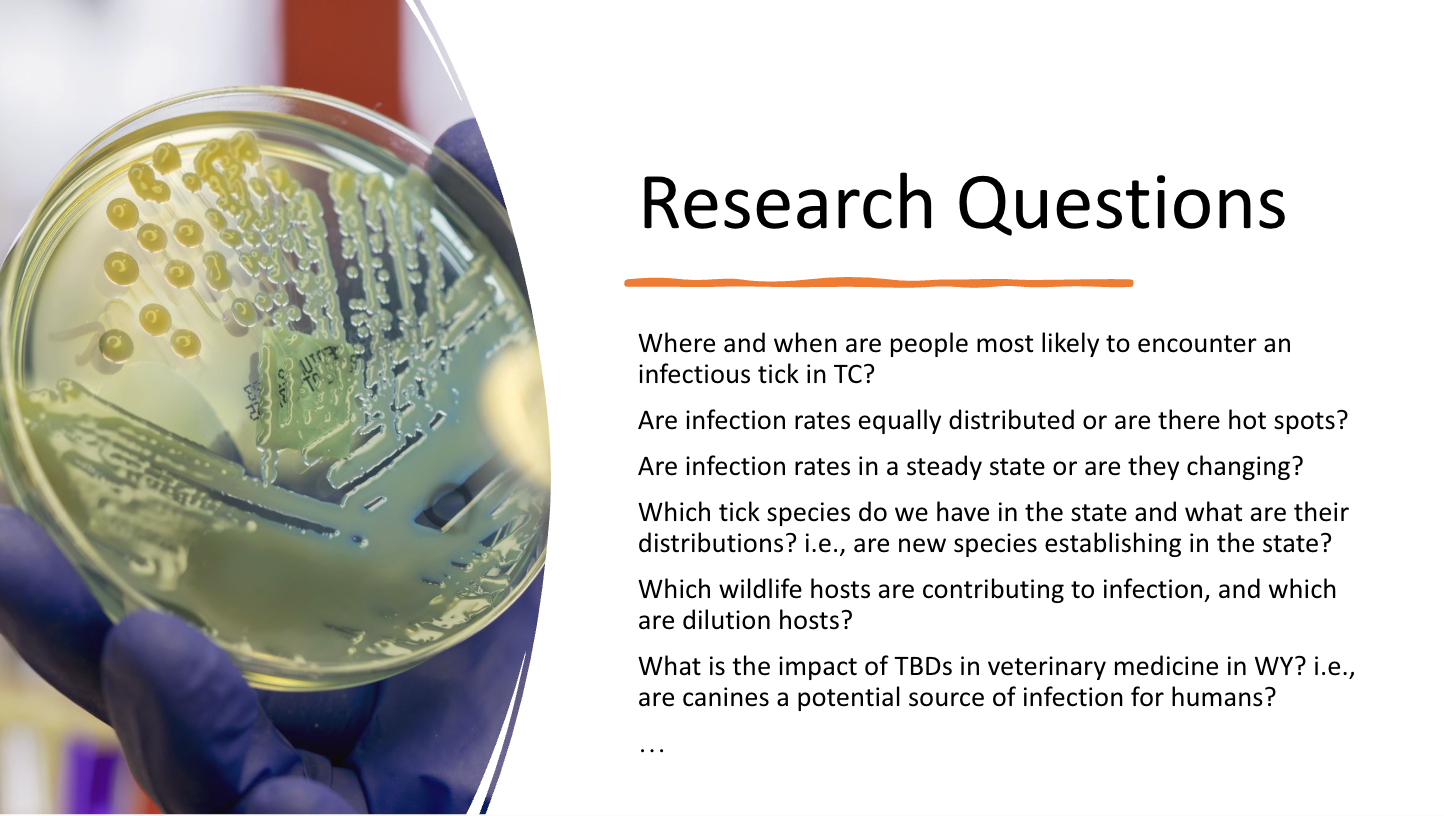

2025 End of Season Tick Surveillance Report + Understanding and Tackling Knowledge Gaps Surrounding Ticks in Wyoming
Thank you to Mikenna Smith, our staff entomologist, and Kelsey Mitchell, our staff biologist, for their contributions to the 2025 Tick Surveillance results, JH Wildlife Symposium presentation, and this article.
2025 End of Season Tick Results
When it comes to wildlife, ticks are one species most of us would rather avoid. But understanding these tiny parasites is essential for protecting both human and animal health in Wyoming.
Here at Teton County Weed & Pest District, our emerging Tick Surveillance research program has concluded its 3rd year and we have a lot of takeaways surrounding tick populations and tick-borne diseases (TBDs) in our state. Despite their growing importance nationwide, Wyoming still has major gaps in basic tick knowledge—from which species are here to what pathogens they may carry. 2025 proved to be our most successful year in tick sampling, with more than 2583 ticks collected in the field — providing real-time insight into tick behavior, pathogen presence, and populations in the Tetons.


JH Wildlife Symposium Presentation: Why Ticks Matter
Ticks are a key part of what the Centers for Disease Control and Prevention (CDC) calls the One Health approach—the idea that the health of people, animals, and our environment are all interconnected. When changes occur in one part of that system—such as in wildlife populations, with land use, or climate change—it can cause a significant ripple effect across the others.
Tick-borne diseases are a perfect example. In recent decades, cases have skyrocketed across the U.S., largely driven by Lyme disease, which surged as forest fragmentation and loss of wildlife diversity disrupted natural ecosystems. These environmental changes created ideal conditions for ticks and their hosts to thrive, illustrating how shifts in land use can directly impact human and animal health.



What We Know (and Don’t) About Ticks in Wyoming
While we know tick-borne diseases are increasing nationwide, Wyoming remains largely a blank spot on the map. Before 2020, There were no dedicated tick research or surveillance programs in the state, meaning we didn’t even have a complete list of the tick species that live here.
We know of at least five TBDs that can occur in Wyoming, but we don’t know how widespread they are—or how often ticks are infected. Surprisingly, many residents don’t even realize that we have ticks here, let alone ones capable of spreading disease.
Building a One Health Collaboration
Our emerging research program aims to fill these knowledge gaps through:
- Surveillance and species identification
- Pathogen testing
- Insecticide susceptibility assessments
- Community outreach and education
We Want to Answer These Key Questions:
- Where are the ticks?
- What species do we have?
- What pathogens are present, and at what rates?
- Are populations and infection rates changing over time?

This work is too big for one team alone, so we’re taking the One Health approach—collaborative, cross-disciplinary, and community-driven. We’re already forming partnerships with local organizations, universities, and government agencies to strengthen this effort.


Our goal is simple: close Wyoming’s tick knowledge gaps and share what we learn to help protect public, animal, and environmental health. Stay tuned into our content as we continue to build this program and continue sharing what we discover about ticks in the Greater Yellowstone Ecosystem.
